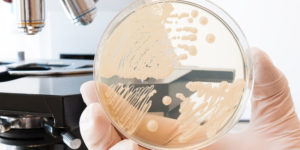
רפואה סינית כטיפול בפטרת וגינלית

מחלות נשים. דיקור סיני למחלות נשים
דיקור סיני מומלץ במיוחד לטיפול במחלות נשים
הרפואה הסינית מתמודדת בהצלחה עם מחלות נשים ויעילה במיוחד להקלה על כאבים ובמצבים של חוסר איזון כגון בעיות מחזור, תופעות גיל המעבר, פוריות, אי יציבות נפשית ועוד
רפואה סינית מטפלת בנשים. ראיון עם רפאל רוזנסקי
גיל המעבר דיקור סיני לגלי חום וחרדות
כאבי מחזור – גלי חום – הפרעות במחזור החודשי – פטרת וגינלית